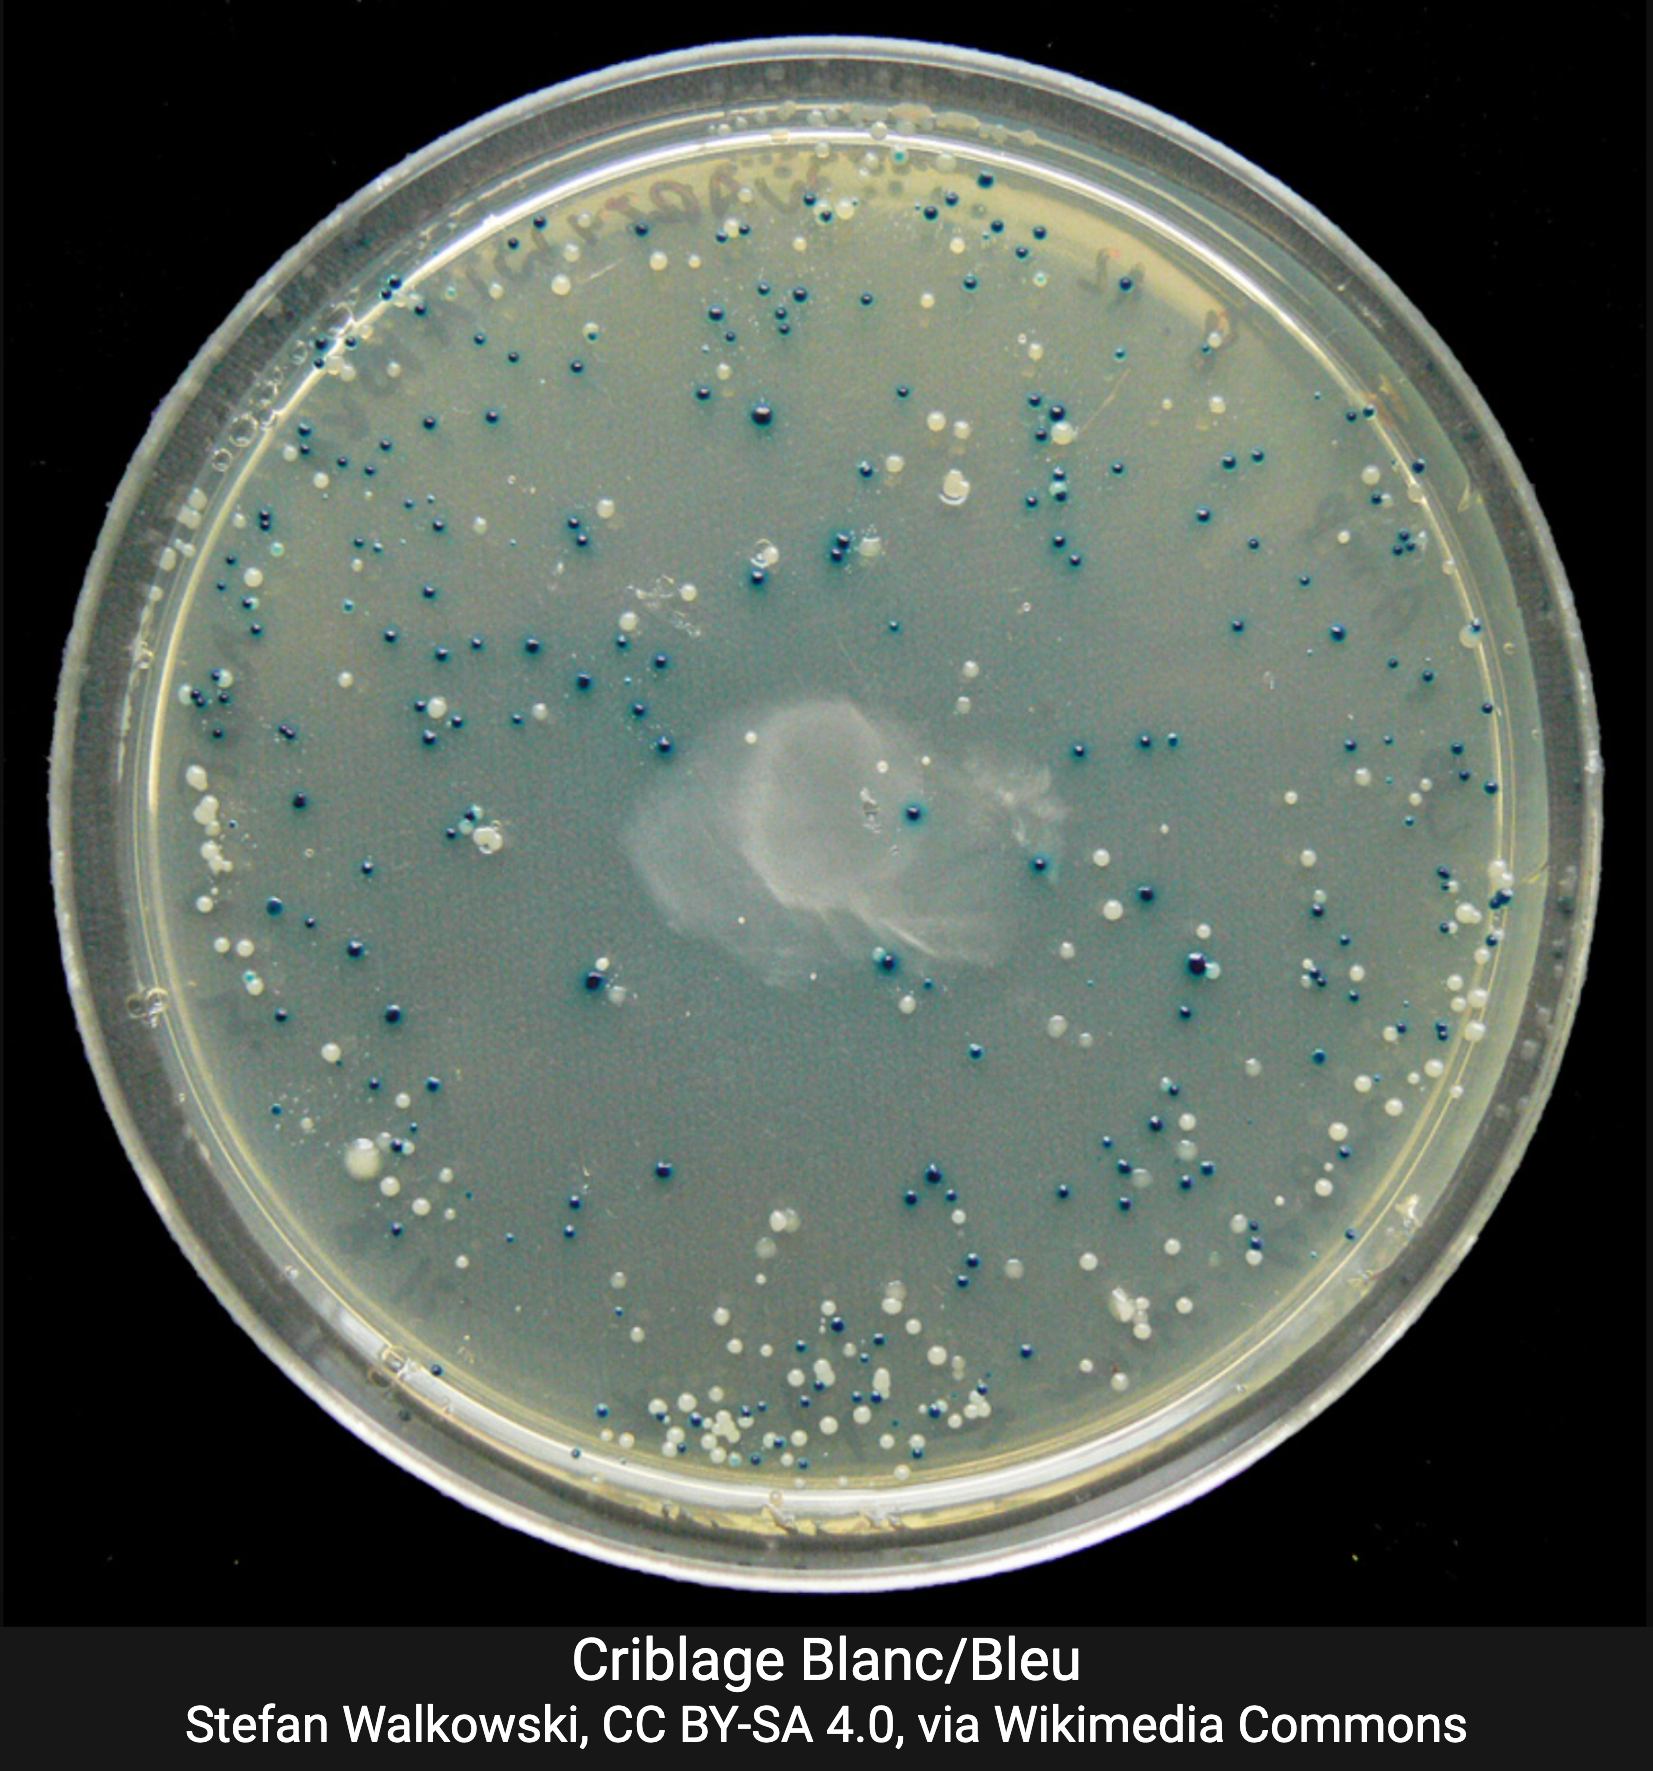

Criblage des Clones recombinants
Après l'étape de sélection, toutes les colonies survivantes contiennent un plasmide, mais:
- certaines contiennent un plasmide recombinant (avec insert)
- d'autres contiennent un plasmide non recombinant, résultant d'une recircularisation du vecteur.
Le criblage permet d'identifier spécifiquement les clones contenant l'ADN d'intérêt. Il existe différentes méthodes de criblage.
Criblage par PCR
Après sélection, une petite quantité de cellules est prélevée pour réaliser une PCR. Les amorce utilisées sont généralement:
- soit spécifiques du gène d'intérêt,
- soit positionnées de part et d'autre du site multiple de clonage (MCS).
La taille de l'amplicon visualisé après électrophorèse, permet de déterminer la présence ou l'absence de l'insert.
Test blanc/bleu
Le vecteur utilisé contient le gène lacZ qui code pour la ß-galactosidase, dont le MCS est intégré à la séquence.
- Un plasmide vide conserve l'activité de la ß-galactosidase
- L'insertion de l'ADN d'intérêt inactive le gène lacZ.
Les bactéries sont cultivées sur un milieu qui contient:
- le substrat chromogène X-Gal,
- l'IPTG, inducteur de l'expression de lacZ.
Ainsi:
- colonies bleues : plasmides vides
- colonies blanches : plasmide recombiant.
Crible « négatif » : inactivation d'un gène de résistance
Le criblage négatif repose sur l'inactivation d'un gène de résistance à un antibiotique présent dans le vecteur suite à l'insertion de l'ADN d'intérêt.
C'est le même principe que le crible blanc-bleu vu précédemment.
Dans ce cas le vecteur possède deux gènes de résistance, par exemple à l'ampicilline et à la tétracycline. Si l'ADN d'intérêt est inséré dans le gène de résistance à la tetracycline, les bactéries transformées peuvent être cultivées sur un milieu contenant l'ampicilline, ce qui permet de sélectionner les bactéries qui ont intégrées un plasmide. Les colonies obtenues sont ensuite répliquées à l'aide d'un tampon sur un milieu contenant la tétracycline (replica plating).
On observe alors que certaines colonies n'apparaissent plus dans la boite avec tétracycline, ce sont les bactéries qui contiennent un plasmide recombinant avec un gène de résistance à la tétracycline inactivé.
Il suffit alors d'aller rechercher ces colonies sur la boite avec ampicilline.
Bien que cette méthode nécessite une étape supplémentaire de « replica plating » est simple à réaliser et ne nécessite pas de réactifs comme pour le test blanc/bleu.
Criblage par hybridation (Southern Blot)
Une sonde d’ADN marquée, complémentaire de l'insert, est utilisée pour détecter sa présence après électrophorèse et transfert de l'ADN sur membrane.
Cette méthode est très spécifique mais peu utilisée en routine.
Criblage par fluorescence
Le vecteur utilisé contient un gène qui code pour une protéine fluorescente (par exemple la GFP). L'insert est cloné en phase avec le gène fluorescent.
Les bactéries qui expriment la protéine recombinante émettent une fluorescence détectable.
Le cadre de lecture de l'insert doit être en phase avec celui du gène fluorescent pour obtenir une protéine hybride fonctionnelle.
Comparaison des méthodes de criblage
| Méthode | Principe | Avantages | Limites |
| PCR | Amplification de l'insert | simple, rapide, peu coûteuse, très sensible, vérifie la taille et possiblement l'orientaion de l'insert | Risque de contaminations |
| Test Blanc/Bleu | Inactivation du gène lacZ | Rapide, économique, criblage de nombreuse colonies simultané | Ne confirme ni la taille ni l'orientation de l'insert |
| Crible négatif | Inactivation d'un gène de résistance | Simple, pas de réactif | Etape supplémentaire, nécessite deux marqueurs |
| Southern blot | Hybridation avec sonde marquée | Très spécifique | Long, coûteux, non adapté au criblage de routine |
| Fluorescence | Coexpression avec la protéine recombinante | Permet aussi de quantifier l'expression | Réservé au clonage d'expression |



